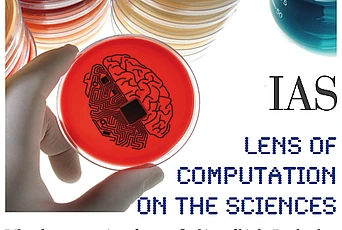

In this talk, Jennifer Chayes, Distinguished Scientist and Managing Director of Microsoft Research New England and New York City, looks quite generally at some of the models we are using to describe networks, processes we are studying on the networks, algorithms we have devised for the networks, and finally, methods we are developing to indirectly infer network structure from measured data. In particular, she discusses models and techniques that cut across many disciplinary boundaries.